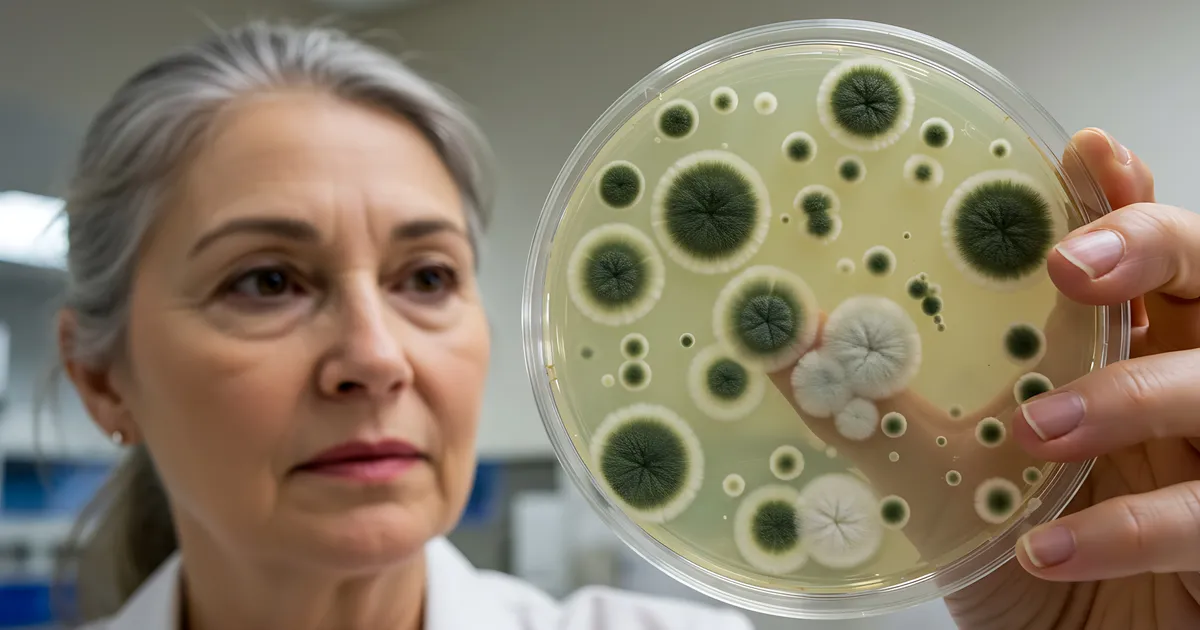
RAVIMID JÄÄVAD HÄTTA ⟩ See levinud haigus allub ravile järjest halvemini

PIKAAJALINE UURING ⟩ Need taimsed ühendid aeglustavad südamehaiguste teket
Tee, kohv, marjad, kakao ja pähklid – kui need toidud on sinu menüüs sagedased külalised, teed oma südamele suure teene. Värske, kümme aastat kestnud uuring kinnitab, et polüfen...